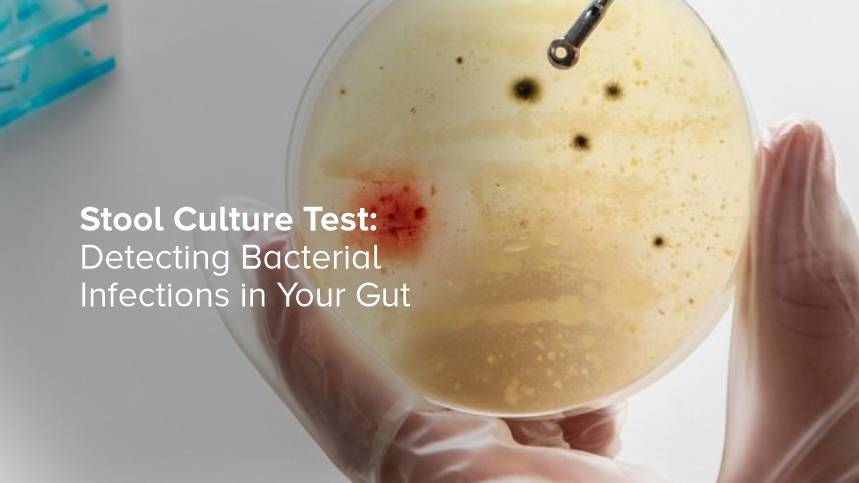
Stool Culture Test: Detecting Bacterial Infections in Your Gut

Cmprehensive Health Care
Your trusted partner in diagnostic and wellness
Home / Blog
Latest Blog
High Absolute Lymphocyte Count (Lymphocytosis): What It Could Indicate
High Absolute Lymphocyte Count (Lymphocytosis): What It Could Indicate An elevated...
05-12-2025
Low Absolute Lymphocyte Count (Lymphocytopenia): Causes and Symptoms
Low Absolute Lymphocyte Count (Lymphocytopenia): Causes and Symptoms Lymphocytes...
05-12-2025
What is Absolute Lymphocyte Count (ALC) and Why It Matters
What is Absolute Lymphocyte Count (ALC) and Why It Matters Absolute Lymphocyte...
05-12-2025
What Does a Pneumonia Blood Test Detect?
What Does a Pneumonia Blood Test Detect? Pneumonia affects millions of people...
05-12-2025
Bacterial vs Viral Pneumonia – What’s the Difference?
Bacterial vs Viral Pneumonia – What’s the Difference? Pneumonia...
05-12-2025
What Is the Lung Cancer Basic Panel (NGS) and How Does It Help in Early Detection?
What Is the Lung Cancer Basic Panel (NGS) and How Does It Help in Early Detection? Lung...
05-12-2025
How a Focused Hereditary Cancer Panel Helps Identify Your Genetic Cancer Risk
How a Focused Hereditary Cancer Panel Helps Identify Your Genetic Cancer Risk Understanding...
05-12-2025
Vitamin B1 Test: Why Thiamine Levels Matter for Your Health
Vitamin B1, also known as thiamine, is an essential nutrient that plays a critical role...
27-10-2025
Vitamin A Deficiency: Signs, Symptoms, and How to Prevent It
Vitamin A is an essential fat-soluble vitamin that plays a vital role in maintaining good...
27-10-2025
Fatty Acids Test: When Your Doctor Might Recommend It
Fatty acids play a crucial role in maintaining optimal health, yet many people remain unaware...
27-10-2025
What is a Clorazepate Test and Why is it Done?
Clorazepate is a prescription medication that belongs to the benzodiazepine class of drugs....
27-10-2025
Magnesium Deficiency: Symptoms You Shouldn’t Ignore
Magnesium is one of the most vital minerals in the human body, playing a role in over 300...
27-10-2025
What is a Glucose Tolerance Test and Why is it Important?
The glucose tolerance test stands as one of the most important diagnostic tools in modern...
27-10-2025
How Often Should You Get a Clozapine Blood Test?
Clozapine represents one of the most effective antipsychotic medications available for treating...
27-10-2025
Low Calcium: Symptoms, Causes, and Treatments
Calcium is an essential mineral vital for numerous bodily functions, from building strong...
27-10-2025
High Calcium Levels: Causes, Symptoms, and Health Risks
Calcium is an essential mineral vital for maintaining strong bones, facilitating nerve transmission,...
27-10-2025
Saturated vs Unsaturated Fatty Acids: What’s the Difference?
Fats often get a bad reputation, but the truth is that not all fats are created equal. Some...
27-10-2025
Nutrient Deficiencies in Children: What Parents Should Know
As a parent, ensuring your child receives the right nutrition is a top priority. A balanced...
27-10-2025
Iron Deficiency in Women: Symptoms, Causes, and Treatments
Iron is an essential mineral that plays a crucial role in the production of hemoglobin,...
27-10-2025
Early Signs of Vitamin B1 Deficiency
Vitamin B1, also known as thiamine, is an essential nutrient that plays a critical role...
27-10-2025
NS1 vs Antibody Tests: Which Dengue Test is Right for You?
Dengue fever is one of the most common mosquito-borne viral infections in tropical and subtropical...
27-10-2025
Typhoid Test: What is It, When To Be Taken & Side Effects
Typhoid fever remains a significant global health concern, particularly in developing regions...
27-10-2025
Bone Marrow Biopsy vs. Bone Marrow Aspiration: Key Differences
Two primary methods exist for examining bone marrow tissue: bone marrow biopsy and bone...
27-10-2025
Why Doctors Recommend an MP Test for Fever Diagnosis
A fever is one of the body's most common responses to infection, signaling that your immune...
27-10-2025
Seasonal vs. Food Allergies: What's the Difference?
Allergies occur when the body's immune system reacts to a substance that is normally harmless....
27-10-2025
Respiratory Tract Infection Profile (IgG): Why This Test Matters for Your Lung Health
Your lungs are vital organs that work tirelessly to provide oxygen to your body and remove...
27-10-2025
What Rheumatoid Factor and ANA Tests Reveal About Your Joints
Joint pain and stiffness can signal various underlying health conditions, making proper...
27-10-2025
Tests for Bacterial Meningitis
Bacterial meningitis represents one of the most serious medical emergencies requiring immediate...
27-10-2025
Why Regular Diabetes Screening is Important for Seniors
As we age, our bodies undergo numerous changes, and our risk for certain health conditions,...
27-10-2025
Essential Health Checkups Every Senior Citizen Should Take Annually
As we age, our bodies undergo significant changes, making proactive healthcare more important...
27-10-2025
Foods That Help Boost Hemoglobin Naturally
Hemoglobin plays a vital role in keeping our body healthy and energetic. It is the iron-rich...
27-10-2025
Common Health Conditions You Can Detect with a Home Blood Test
Home blood testing has transformed how we monitor our health, making medical diagnostics...
01-10-2025
Vitamin C During Pregnancy – Why It’s Important for Mother & Baby
A well-balanced diet is fundamental to a healthy pregnancy, providing the essential nutrients...
01-10-2025
Foods Rich in Vitamin B12: A Complete Guide for Better Nutrition
Vitamin B12 stands as one of the most critical nutrients for optimal health, yet millions...
01-10-2025
Vitamin B1 Deficiency: Symptoms, Causes, and Treatment
Vitamin B1, also known as thiamine, is an essential nutrient that plays a critical role...
01-10-2025
High Chloride Levels in Blood: Causes, Symptoms, and Treatment
Elevated chloride levels in blood, medically termed hyperchloremia, represent a significant...
01-10-2025
Prediabetes vs. Diabetes: How blood test Helps You Stay in Control
Early detection through regular blood testing represents your most powerful tool for preventing...
01-10-2025
Factors Affecting Creatinine Levels in Spot Urine
Creatinine testing serves as a fundamental diagnostic tool for assessing kidney function...
01-10-2025
Fructosamine Levels and Their Impact on Your Overall Health
Managing blood sugar is a critical aspect of overall health, particularly for individuals...
01-10-2025
Why Doctors Recommend a Plasma Lactate Test
When a doctor recommends a specific diagnostic test, it is natural to have questions. If...
01-10-2025
Common Causes of Low Platelet Count (Thrombocytopenia) and How to Manage It
Low platelet count, medically termed thrombocytopenia, affects millions of people worldwide...
01-10-2025
High Potassium (Hyperkalemia): Symptoms, Causes, and Risks
Potassium is an essential mineral that plays a vital role in the proper functioning of your...
01-10-2025
Why Doctors Recommend Vitamin C Blood Tests
Vitamin C deficiency affects millions of people worldwide, yet many individuals remain unaware...
01-10-2025
Potassium Serum Test: Why This Electrolyte Matters for Your Health
Potassium plays a crucial role in maintaining your body's essential functions, yet many...
01-10-2025
Platelet Count Test for Dengue, Malaria, and Other Infections: Why It’s Crucial
When fever strikes accompanied by fatigue and body aches, determining the underlying cause...
01-10-2025
Normal Platelet Levels: When to Worry About High or Low Counts
Platelets are tiny, colorless cell fragments in our blood that play a crucial role in forming...
01-10-2025
When Should You Get a Serum Chloride Test?
A serum chloride test measures the amount of chloride in your blood, providing essential...
01-10-2025
Common Myths About Vitamin B12 Deficiency
Vitamin B12 deficiency affects millions of people worldwide, yet misinformation continues...
01-10-2025
Plasma Lactate Levels: Normal Ranges and What They Mean
Plasma lactate levels serve as a critical biomarker in clinical diagnostics, providing healthcare...
01-10-2025
How the Fructosamine Test Helps in Managing Diabetes
Managing diabetes effectively requires consistent monitoring of blood glucose levels over...
01-10-2025
Estradiol Blood Test: Purpose, Procedure, and Normal Ranges
Estradiol is a key form of estrogen, a primary female sex hormone, though it is present...
30-09-2025
Estradiol and Hormonal Balance: How It Affects Your Body
Estradiol stands as the most potent form of estrogen in the human body, playing a fundamental...
30-09-2025
Top Signs You Should Get a Prediabetes Test Today
Prediabetes affects approximately 96 million American adults, yet more than 80% remain unaware...
30-09-2025
Electrolyte Imbalance: How Urine Sodium, Potassium, and Chloride Tests Help in Diagnosis
Maintaining the body's internal balance is crucial for overall health, and electrolytes...
30-09-2025
Serum Chloride Test: Purpose, Procedure, and Normal Ranges
The serum chloride test is a fundamental blood test that measures chloride levels in your...
30-09-2025
Troponin-T Test Procedure: Complete Step-by-Step Guide
Troponin-T testing represents one of the most critical diagnostic procedures in modern cardiology....
30-09-2025
Troponin-T Tests: Quantitative vs Qualitative Explained
Heart health diagnostics have advanced significantly with the development of troponin testing....
30-09-2025
RF-IgA vs RF-IgM: What’s the Difference and Why It Matters
Rheumatoid Factor (RF) testing plays a crucial role in diagnosing autoimmune conditions,...
30-09-2025
Electrolyte Disorders: Causes, Symptoms, and the Role of Urine Spot Tests in Early Detection
Electrolyte disorders affect millions of people worldwide, yet many cases remain undiagnosed...
30-09-2025
How to Prepare for a Lactose Tolerance Test – A Step-by-Step Guide
If you experience digestive discomfort after consuming dairy products, your doctor may recommend...
30-09-2025
Vitamin B12 Injections vs. Supplements: Which is Right for You?
Vitamin B12 deficiency affects millions of people worldwide, yet many remain unaware of...
30-09-2025
What is a Lactose Tolerance Test and Why is it Done?
Many people experience uncomfortable digestive symptoms after consuming dairy products,...
30-09-2025
When and Why is the Sirolimus Blood Test Recommended?
Sirolimus, also known as rapamycin, represents a critical immunosuppressive medication primarily...
30-09-2025
Who Is at Risk of Vitamin B12 Deficiency?
Vitamin B12 deficiency affects millions of people worldwide, yet many remain unaware they...
30-09-2025
Top 10 Health Benefits of Vitamin B1 (Thiamine)
Vitamin B1, scientifically known as thiamine, plays a crucial role in maintaining optimal...
29-09-2025
Top 10 Natural Sources of Vitamin C You Should Include in Your Diet
Vitamin C stands as one of the most essential nutrients your body requires for optimal health....
29-09-2025
Best Plant-Based Sources of Vitamin B12 – What You Need to Know
For individuals following a plant-based diet, ensuring adequate intake of all essential...
29-09-2025
Why Regular Vitamin B12 Testing is Important for Your Health
Vitamin B12 is an essential nutrient that plays a critical role in maintaining your body's...
29-09-2025
CUE Test Results – What They Mean for Your Health
The CUE test, also known as the Comprehensive Urinalysis Examination, serves as a fundamental...
29-09-2025
Top 10 Benefits of Getting a Blood Test at Home
Healthcare has evolved significantly, bringing medical services directly to your doorstep....
29-09-2025
How ESR Test Helps Detect Inflammation in the Body
The Erythrocyte Sedimentation Rate (ESR) test stands as one of the most fundamental diagnostic...
29-09-2025
Creatinine Spot Urine Test: Purpose, Procedure, and Benefits
Kidney function assessment plays a crucial role in maintaining overall health, and the creatinine...
29-09-2025
Urine Routine & Microscopy (CUE) Test: What You Need to Know
Urine testing represents one of the most fundamental diagnostic tools in modern medicine....
29-09-2025
BRCA1 and BRCA2 Mutations: Why They Are Crucial in Ovarian Cancer Detection
Genetic mutations in BRCA1 and BRCA2 genes represent one of the most significant risk factors...
27-08-2025
Family History and Breast Cancer: How NBN Gene Mutations Affect Risk
Family history serves as one of the most significant risk factors for breast cancer...
27-08-2025
Can CDH1 and TP53 Genes Predict Aggressive Breast Cancer?
Breast cancer remains one of the most significant health challenges facing women worldwide,...
27-08-2025
How CRP and ESR Help Detect Lung Infections Early
Lung infections represent one of the most serious health challenges globally, affecting...
27-08-2025
Stool Culture Test: Detecting Bacterial Infections in Your Gut
Our digestive system is home to a vast community of microorganisms—most of which are...
29-04-2025
Non-Alcoholic Fatty Liver Disease and Abnormal LFTs: A Growing concern
Liver health often takes a backseat when it comes to routine checkups, yet this vital organ...
29-04-2025
Abnormal LFTs: When Should You Be Concerned?
Liver plays a crucial role in our body's overall health—it helps process nutrients,...
29-04-2025
How Stool Tests Help Diagnose Celiac Disease and Gluten sensitivity
Before we get into how stool tests work, let’s quickly understand what celiac disease...
29-04-2025
OTP Verification
Please Enter OTP
Enter your details
Set Location
Share Your Feedback
Cart
Tests added here are for 1 member. You can add or remove members in the next step.
 Get 15% OFF on 1st order above ₹100 Use code: AMPATH
Get 15% OFF on 1st order above ₹100 Use code: AMPATH






-and-Why-It-Matters.jpg)





















--Why-This-Test-Matters-for-Your-Lung-Health.jpg)
-and-ANA-–-What-They-Reveal-About-Your-Joints-07.jpg)













-and-How-to-Manage-It.jpg)
--Symptoms,-Causes,-and-Risks.jpg)






















.jpg)







 Test – Purpose, Procedure, and Importance.jpg)